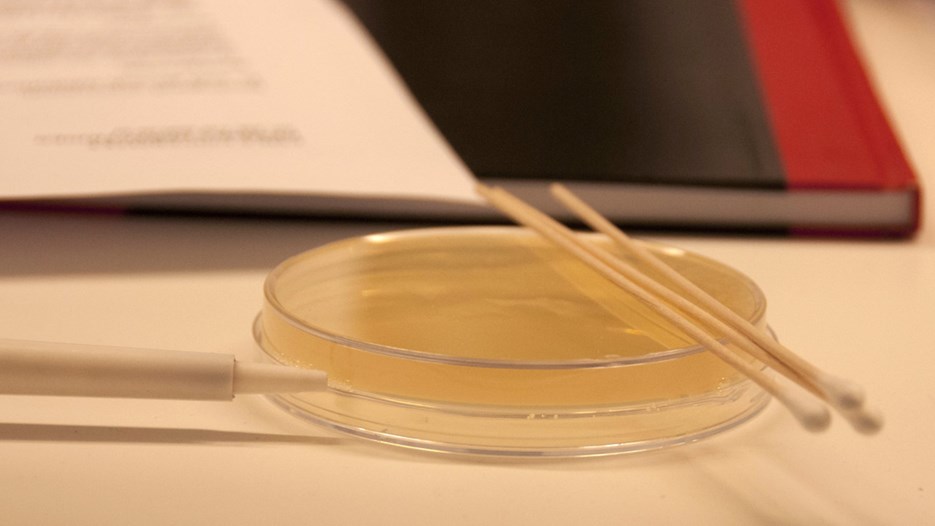
Bild på anteckningar och petriskål

A new medicine has to be efficient in treating the targeted disease. During one of their first practical sessions in the lab, the Life Science students get a preview of how the medicines of tomorrow are being developed. Which of the two studied molecules have anti-bacterial effect? What type of molecule is that?

The Bachelor's programme in Life Science is one of a few education programmes at basic level at Umeå University which is given in English. In the lab most students speak English with each other. During a lab, the students work with molecules for tomorrow's medicines.
Image Anna-Lena Lindskog
Emil Johansson and Mikael Långström have to calculate a bit before they can start mixing a solution that hopefully kills E coli bacteria.
Image Anna-Lena Lindskog
The Life Science programme covers a broad spectrum of chemistry and molecular biology.
Image Anna-Lena Lindskog
Li Linfeng and Tahei Suzuki consider their next step during the lab with medicines of tomorrow.
Image Anna-Lena Lindskog
Donal Barrett works by the fume cupboard during the lab Medicines of tomorrow.
Image Anna-Lena Lindskog
Writing up a report. Isabelle Davour and Irma Dittrich work together.
Image Anna-Lena Lindskog
During one of their first labs the students in the Life Science programme get a glimpse of how tomorrow's medicines are created.
Image Anna-Lena Lindskog
Emil Johansson and Mikael Långström have to calculate a bit before they can start mixing a solution that hopefully kills E coli bacteria.

The Life Science programme covers a broad spectrum of chemistry and molecular biology.

Li Linfeng and Tahei Suzuki consider their next step during the lab with medicines of tomorrow.

Donal Barrett works by the fume cupboard during the lab Medicines of tomorrow.

Writing up a report. Isabelle Davour and Irma Dittrich work together.
During one of their first labs the students in the Life Science programme get a glimpse of how tomorrow's medicines are created.
– Yesterday we separated two different substances (molecules) and one of them is supposed to work as an antibiotic, says Isabelle Davour. It will be exciting to se how it goes.
Curiosity about how things are working at molecular and atomic level and a possible future as a scientist made her chose the Life Science programme.
– I have always liked chemistry and biology in school. The reason for choosing this particular programme in Umeå was mainly because it's given in English and the fact that I wish to try working abroad afterwards.
In the room next door Emil Johansson and his lab mate Mikael Långström are discussing in front of their notebooks. They are in the middle of calculating the amounts of different substances to mix in order to end up with the right concentration of their hopefully anti-bacterial solution.
– Yesterday was the first practical session in the lab, so a number of things are quite difficult, says Emil. It's probably not that difficult, but it was a long time ago since we had chemistry.
Soon they are on the right track and disappear into a room to do some weighing, but Mikael suddenly returns.
– I forgot to take my gloves on!
The Life Science programme is one of few educational programmes at basic level that is given in English. In the lab most students are speaking English with each other and the teacher Lina Mörén gives her instructions in English.
– I chose Umeå since it was the only high quality university that offered a bachelor programme in chemistry in English, says Li Linfeng from Beijing, China.
He is planning to stay in Umeå for his whole education, maybe even a master's programme, and he likes it already.
– Umeå is very calm and peaceful, not so many cars. I like the fact that you can go by bike everywhere, says Li Linfeng.
Andreas Carlström has his goal set to become a scientist.
– I already have a master's exam in sports medicine and during that time my interest for research has grown more and more. I would really like to do research within sports physiology and for that I need a deeper knowledge in chemistry and molecular biology, he says. Right now I am taking single courses in Life Science, at least for a year.
The chemistry subject has for a number of years had problems in attracting students. Why is it like that, you think?
– I believe that many get scared off since they think that chemistry is much harder than it actually is. In school you don't get any good idea or examples of how chemistry can be used in real life and what it is good for. I think it was the same for me, but during my university studies I have realized that chemistry is present everywhere and important for everything. That's what makes it so fun and fascinating.
A couple of days later the students have made significant progress with their experiments. Isabelle Davour and her lab mate Irma Dittrich are in the process of synthetizing, make more of, the molecule that proved to be a killer of the E. coli bacteria in the first experiment.
– After this we will test if the synthetized molecule works as well against the bacteria. Otherwise there will be no patent for us, Isabelle says and laughs.
The work with developing an anti-bacterial compound has been interesting, she thinks. At the same time, the work in the lab has not been all that easy.
– You have to be very accurate and think in advance for the next step of the lab. Otherwise you risk doing something wrong and have to start all over again. I think it will work better the next time, you learn from your mistakes as well, says Isabelle.
Anna-Lena Wehn, exchange student from Frankfurt, Germany, is concentrating, with her hands inside the fume hood, for the last step of the synthesis of the anti-bacterial compound.
She has visited Umeå before and really wanted to return as a student. It was made possible since Umeå university and her university in Germany are partner universities.
– I have studied for two years in Germany, mostly biotechnology. I really enjoy being in Umeå. Here you get more time to focus on different themes and we work more in groups than we did at home. Last week for example, we were studying the immune system and made a presentation for the others at the end. It is good practice to work that way, in Germany it was more common with only lectures and labs.
What are your plans for the future?
– I think I will stay here for one year, but I will most likely return to Sweden later to finish my master's exam. After that I believe that I am aiming to become a scientist in academia rather than working in industry.